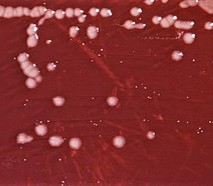

Tentang MaxiFarm


Sebagai sebuah terobosan teknologi pemupukan dengan pendekatan biologi, MaxiFarm mampu menciptakan sebuah stimulant dengan memberdayakan sejumlah mikroba khusus. Mikrobamikroba tersebut sangat dibutuhkan dalam proses pe nyediaan hara makro dan mikro: Azospirillum Sp; Azotobacter Sp; mikroba pelarut P; lactobacillus Sp; dan mikroba pendegra dasi selulosa.
Apa yang Dilakukan Mikroba pada MaxiFarm?
Pupuk hayati MaxiFarm merupakan jenis pupuk yang secara unik mampu menghimpun sejumlah mikroba yang bekerja untuk penyediaan hara makro dan mikro serta dalam jangka panjang dapat mempengaruhi kesuburan tanah. Meski demikian ada juga jenis mikroorganisme yang merugikan. Inovasi riset yang dilakukan pada MaxiFarm berhasil menghimpun jenis-jenis mikroorganisme yang memberikan manfaat dengan fungsi masing-masing sebagai berikut:

Azotobacter Sp
Berfungsi sebagai mikroba penambat N (nitrogen) dari udara bebas.

Azoospirilium Sp
Berfungsi sebagai penambat N (nitrogen).
Pseudomonas Sp
Berfungsi untuk mendegradasi berbagai jenis hidrokarbon. Dan sebagai pemacu pertumbuhan dan pengendali hayati fungi patogen akar tanaman.

Bacillus Sp
- Meningkatkan penyerapan nutrisi tanaman
- Mengurangi serangan penyakit akibat jamur
- Menghasilkan zat pengatur tumbuh (vito hormone)

Lactobacillus Sp
Berfungsi untuk membantu proses fermentasi bahan organik menjadi senyawasenyawa asam laktat yang dapat diserap tanaman.

Mikroba Penambat N
Berfungsi mengikat Nitrogen bebas di udara dan mereduksinya menjadi senyawa Amonia dan Ion Nitrat oleh bantuan Enzim Nitrogenase.

Mikroba Pelarut Fosfat
Berfungsi untuk melarutkan fosfat yang terikat dalam mineral hara tanah agar tersedia dan mudah diserap oleh tanaman, Pseudomonas fluorescens (pengurai pertisida) dapat menghasilkan enzim pengurai yang berfungsi untuk memecah mata rantai dari zat-zat kimia sistemik (pestisida) yang tidak dapat terurai oleh mikroba lainnya.

Mikroba Selulolitik
Pendegradasi bahan organik / pembusukan bahan organik.

Mikroba Perombak Bahan Organik
Berfungsi sebagai pengendali hayati dan juga dapat menangkal kresek pada padi.
Selain mengandung 9 Mikroorganisme di atas, MaxiFarm juga mengandung 4 Hormon Pertumbuhan Alami, yaitu:
Hormon IAA
Berfungsi adalah membantu dalam proses mempercepat pertumbuhan.
Hormon Giberlin
Berfungsi mengatur perkecambahan, pemanjangan batang, pemicuan pembungaan.
Hormon Kinetin
Berfungsi menunda penuaan pada daun.
Hormon Zeatin
Berfungsi memperbaiki, mempermudah, mempercepat dan meningkatkan proses pembelahan sel.
Manfaat untuk Pertanian / Perkebunan
- Mengurangi Penggunaan Pupuk Kimia hingga 50%.
- Memacu pertumbuhan batang dan memperbanyak percabangan tanaman.
- Mempercepat pertumbuhan tanaman, daun tebal dan kuat, serta batang lebih kuat
- Meningkatkan aktivitas mikroorganisme yang positif di dalam tanah.
- Menyehatkan bibit tanaman daun, bunga dan buah.
- Menjaga keseimbangan dan kelangsungan siklus alami unsur hara dalam tanah.
- Memicu pertumbuhan tunas dan anakan.
- Menekan hama dan penyakit tanaman.
Manfaat untuk Perikanan
- Meningkatkan dan menjaga mutu air tambak / kolam.
- Menekan perkembangan bakteri pathogen didalam tanah dan air tambak / kolam.
- Meningkatkan kekebalan dan kesehatan udang / ikan terhadap hama penyakit.
- Meningkatkan produktipitas tambak / kolam.
- Meningkatkan mutu dan jumlah plankton pada air tambak / kolam.
- Meningkatkan kualitas dan kuantitas udang / ikan.
- Panen relatif lebih cepat.
- Menekan potensi pencemaran pada lingkungan tambak / kolam.
- Rasa ikan lebih gurih dan lezat karena tidak bau tanah.
Manfaat untuk Peternakan
- Tidak perlu lagi menggunakan antibiotik.
- Meningkatkan nafsu makan ternak.
- Meningkatkan angka kehidupan (SR) dan meningkatkan efisiensi pakan (RCR).
- Meningkatkan pencernaan pakan, sehingga nutrisi yang terdapat pada pakan dapat mudah terserap oleh sistem pencernaan.
- Merangsang ternak untuk meningkatkan kekebalan tubuhnya.
- Pertambahan berat badan per hari (ADG) signifikan.
- Mutu daging menjadi lebih baik
- Lingkungan terjaga, kandang tidak menyebarkan aroma yang menyengat.
- Sistem pencernaan akan lebih optimal sehingga selera makannya tinggi.
- Hewan lebih tahan akan penyakit dan cuaca.
- Tingkat kegemukan dan pertumbuhan menjadi tinggi (maksimal).
- Kotoran hewan tidak berbau. Mengurai bau kotoran terutama kotoran unggas hingga 80%
Cara Pemakaian
Secara umum, MaxiFarm digunakan pada 10 – 15 hari setalah tanam (HST).
Cara penggunaan atau aplikasi pembenah tanah MaxiFarm sangat mudah, yakni:
- Campurkan 1 tutup botol MaxiFarm dengan 1 liter air.
- Bila menggunakan Alat Penyemprot (Sprayer) ukuran 16 liter, maka campurkan 16 tutup botol MaxiHumat dengan 16 liter air.
Bila kurang jelas, silahkan lihat video berikut ini.
Untuk capa penggunaan MaxiFarm pada beberapa jenis tanaman, silahkan lihat pada menu Aplikasi.
Copyright © 2025 PT. Sellerpro Sukses Abadi. All Rights Reserved.